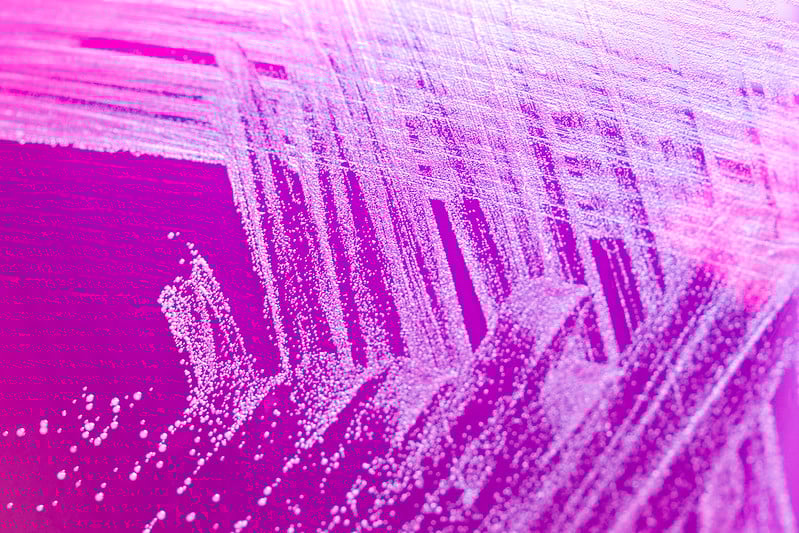
9204114088_31e6ecb999_c
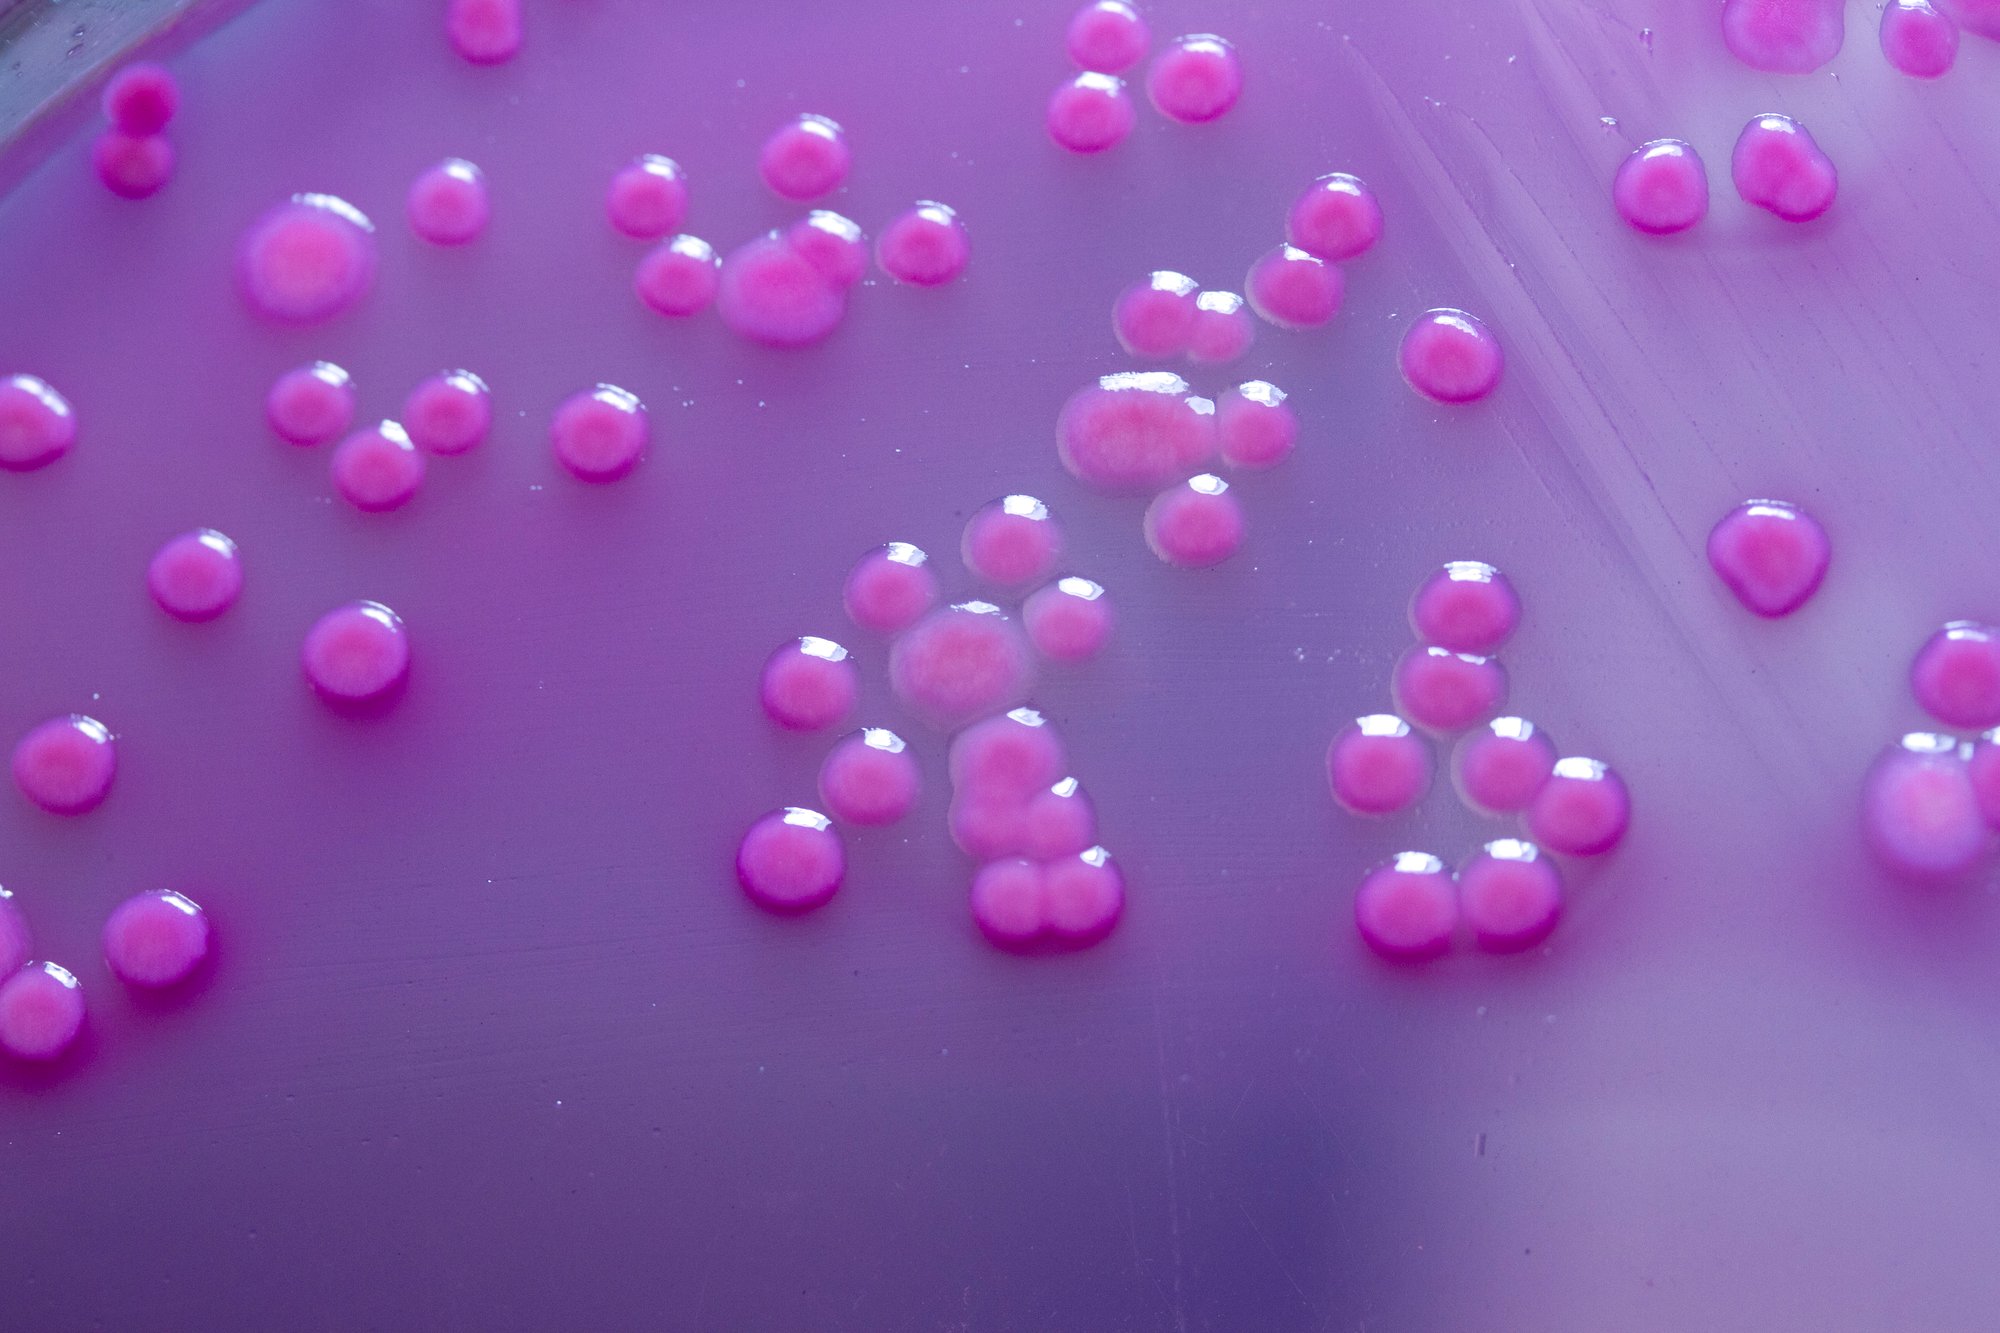
9204115942_2fbc74f099_o

Cada proyecto, desde su concepto hasta su ejecución, nos enseña y nos impulsa a seguir creando junto a quienes confían en nosotros.
%2011.14.19%20p.%20m..png?width=327&height=214&name=Captura%20de%20pantalla%202025-10-19%20a%20la(s)%2011.14.19%20p.%20m..png)
Trabajar con Karla ha sido una de las mejores decisiones en mi proceso de construir mi marca personal. Desde el primer encuentro su compromiso, su escucha genuina y su habilidad para captar mi esencia fueron excepcionales. Con una claridad enorme y una sensibilidad muy fina, me acompañó a definir mi visión y propósito, ayudándome a traducir en palabras lo que antes solo intuía.
Más allá de su profesionalismo impecable, valoro profundamente su presencia humana. En cada sesión me sentí comprendida, acompañada y también impulsada a ir más profundo, a mirar con honestidad y a reconocer mi propia voz. El espacio que crea es seguro, cálido y al mismo tiempo transformador.
Además, ahora he comenzado a trabajar junto a Gabriel Baquero en una estrategia de anuncios que me tiene muy entusiasmada. Gabriel aporta un nivel de conocimiento técnico y una perspectiva estratégica que se sienten muy alineados con todo el proceso que inicié con Karla. Su profesionalismo, su claridad para explicar y su manera respetuosa de acompañar hacen que cada decisión se sienta firme, coherente y bien pensada. Siento que juntos forman un equipo que no solo guía, sino que potencia y expande.
Recomiendo sus servicios sin dudarlo.

Como DJ, me enfrento cada día al desafío de promover mi trabajo y consolidar mi identidad artística en un mundo que avanza a una velocidad imparable. Por eso acudí a Autentimark, un equipo que desde el primer momento comprendió mis necesidades y mi visión como cliente.
Después de un proceso completamente fluido, lograron presentarme una propuesta innovadora, clara y estratégica, diseñada para impulsar mi carrera al siguiente nivel. Su profesionalismo y capacidad de entender lo que un artista realmente necesita me dejaron más que satisfecho.
Los recomiendo totalmente.
Lorem ipsum dolor sit amet, consectetur adipiscing elit, sed do eiusmod tempor incididunt ut labore et dolore magna aliqua.
Lorem ipsum dolor sit amet, consectetur adipiscing elit, sed do eiusmod tempor incididunt ut labore et dolore magna aliqua.
Lorem ipsum dolor sit amet, consectetur adipiscing elit, sed do eiusmod tempor incididunt ut labore et dolore magna aliqua.

Jan 10, 2018 By Admin
Lorem ipsum dolor sit amet, consectetur adipiscing elit, sed do eiusmod tempor incididunt.
Jan 10, 2018 By Admin
Lorem ipsum dolor sit amet, consectetur adipiscing elit, sed do eiusmod tempor incididunt.
Jan 10, 2018 By Admin
Lorem ipsum dolor sit amet, consectetur adipiscing elit, sed do eiusmod tempor incididunt.
Jan 10, 2018 By Admin
Lorem ipsum dolor sit amet, consectetur adipiscing elit, sed do eiusmod tempor incididunt.